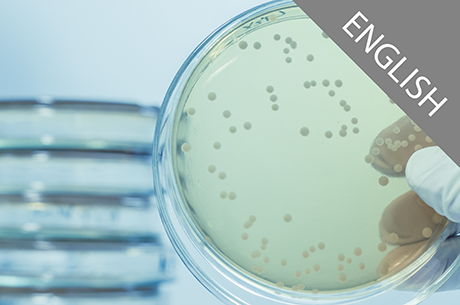
EN 17141 &ndash; European Standard on Biocontamination Control

On-demand Cleanroom Training Course
”EN 17141 – European Standard on Biocontamination Control” is an on-demand Online training course that provides a personal course certificate after course completion.
Course materials included with slides from the course (PDF file to download)
Why choose our On-demand Cleanroom course?
-
Training when it suits you: Each employee can take the course whenever it fits their schedule best.
-
Zero production downtime: No need to halt operations or coordinate massive group schedules.
-
No waiting: Avoid waiting weeks for the next live, scheduled training session. Give your personnel the "Know-why" today
Course author
Course language
The course is in English (No subtitles are currently available).
Looking for our Swedish version? Click here
Course objective
Course target group
Course content
The course consists of 5 Parts, with multiple-choice questions after each Part. The course ties together the different parts of the cleanroom technology, and presents why cleanrooms are being used, contaminants, standards, how cleanrooms work and the impact of humans in the cleanroom.
Course length
The total course length is approximately 130 minutes, consisting of 90 minutes video modules (Parts), followed by multiple-choice questions after each Part, and finally a short survey.
Payment and time to assign/complete the course
You pay for the course license(s)* with card** or request to pay by invoice***.
You get access to the course license(s) directly after approved payment and you have 90 days to assign the course license(s) to the course participant(s) (or yourself), after which the course participant(s) has/have additional 90 days to complete the course. The courses are exclusively sold to legal entities - please see our Terms and conditions, and FAQ for more information.
Team & Volume Discounts
Training your department? Volume discounts are automatically calculated and applied in the cart when purchasing multiple licenses.
Questions?
Please contact us at sales@mcleaned.com for more information.
Don't forget to have a look at our other courses
> See all Courses
* 1 course license per course participant and course
** VISA with Verified by VISA, or MasterCard with MasterCard SecureCode
*** If approved you will receive an Offer and more information via email
Course Content
|
1. Introduction
|
17min |
|
2. Structure, terms and definitions
|
15min |
|
3. Establishment of microbiological control
|
18min |
|
4. Demonstration of microbiological control
|
9min |
|
5. Annex A and Annex B
|
13min |
|
5. Annex C, D, E and Annex F
|
15min |
1. Pay by credit card and assign
1. Pay by credit card and assign 2. Get instant access to
2. Get instant access to  3. Download the personalised
3. Download the personalised